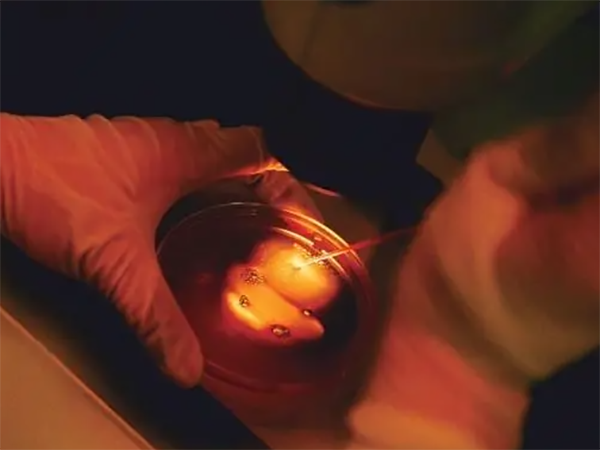

睾丸穿刺

带你了解睾丸穿刺取精数量,原来一般取多少条因人而异
通过睾丸穿刺术能够取出的精子数量每个人都是不同的。一般穿刺取精可用来抽取曲细精管,分离曲细精管中的精子然后用于试管培育受精卵,正常而言一条曲细精管里可能有几十条的精子,至于穿刺能取出多少条精子,这也需要看患者的病情和实际情况如何,一般培育受精卵的话至少也要提取出8-10个精子。一般穿刺取精是适用于无精症或严重弱精症的患者,通过穿刺技术能够从睾丸中获取到一定数量的精子,这样才能用于和卵子结合成受精卵...

800字说清睾丸穿刺取出的精子,精子质量好不好一文搞懂
睾丸穿刺取出的精子并不都是成熟精子,但精子质量方面还是较为不错的。睾丸穿刺取精主要是指通过穿刺针抽取极少量的睾丸组织,然后在显微镜下观察睾丸组织中是否有精子的存在。由于男性的睾丸中缺乏帮助精子发育的营养素,所以取出的精子大部分都是不成熟、静止或稍有晃动的精子。不过患者也不用过于纠结这个问题,医生会对取出的精子进行挑选,选出正常有活力的精子,这个是不会影响到受精卵形成的。因为睾丸穿刺取精技术主要适用...

男性穿刺取精手术大揭秘,一个睾丸能穿刺取精几次有解了
睾丸穿刺取精在一年内可以进行很多次,而且在短期内一个睾丸可穿刺2-3次,不过在穿刺取精中如果未取到精子的话,这个时候就需要再进行检查治疗以及调理了。通常首次穿刺取精可了解生精功能,第二次穿刺可取出精子,只要能够通过穿刺取精获得精子,一般来讲是不需要多次进行睾丸穿刺的。通常睾丸穿刺取精可用于助孕或是诊断疾病,而用于助孕的话,只要能够取出精子就不需要再进行第二次或第三次的取精了。虽然穿刺取精对人体是伤...

睾丸取精做试管婴儿成功率50%得分人,满足这些条件的可行
目前睾丸微穿刺做试管婴儿的成功率是可以达到50%的,但不是每个人都能达到,如果精子质量差,成功率会比较低,此外,影响试管成功的因素很多,如女性子宫环境、胚胎质量、卵子质量和实验室环境,因此具体成功率因人而异,一般年轻的患者做试管的成功率还是比较高的。
睾丸穿刺没有精子只能供精?先做全面体检再做决定更靠谱
男性睾丸穿刺没有精子的话一般只能做供精试管,因为不能产生精子的睾丸是不具备生育能力的,通常是由于睾丸异常导致没有精子产生,建议患者先做个全面的检查,根据病因进行规范治疗,如果在睾丸显微取精手术中找到活动的精子,可以将精子冷冻起来做试管,如果确实没有发现精子,就只能做供精试管了。睾丸穿刺活检可以确定睾丸内是否有精子,主要是明确梗阻性无精子还是原发性无精子,整个过程需要通过穿刺针抽取极少量睾丸组织置于...

一文读懂二代试管什么时候取精,奉上取精子详细流程
做二代试管婴儿什么时候睾丸穿刺取精子较好,是因人而异的。一般情况下,男方穿刺取精和女性取卵都是在同一时间进行,这样能够保证精子和卵子的新鲜度和活性,增加受精率以及配成胚胎的概率。不过由于每个男性的身体情况不同,适合睾丸穿刺取精的时间也是不同的。因此,建议患者积极的配合医生,在医生的专业指导下选择合适的时间到医院完成取精的操作。睾丸穿刺取精是试管婴儿过程中常用的一种取精检查生育能力的方法,相对于其他...

睾丸穿刺取精疼痛感因人而异,局麻后基本没感觉
睾丸穿刺一般是针对做试管无精子患者,需要通过睾丸穿刺的方法,取出精液后化验看是否能用于试管,很多患者会问到睾丸穿刺取精会不会痛,其实是有一丝感觉的,但是都是可以忍受的,通过睾丸穿刺取精都是局部麻醉,正规过程几分钟就完成了。至于睾丸穿刺需要做几次就要看精子的质量问题了,如果精子治疗好的话在试管婴儿实施前做一次就行,取精后冷冻起来,然后在试管婴儿取卵后解冻精子,培养授精,有的会出现做两次的情况,一次是...

睾丸穿刺术前准备工作要记清,早餐饮食可要注意这些禁忌
二代试管男性睾丸穿刺取精前是可以喝水吃早餐的。在睾丸穿刺取精前,无论男性是空腹还是饭后都不会影响精子的质量,只是为了取出更多可用的精子,男性可以适当的吃些蛋白质和精氨酸丰富的早餐,如鸡蛋、豆浆、深海鱼类,及牛羊肉等食物,同时还要避免吃辛辣刺激性食物,确保取出精子的健康。二代试管做睾丸穿刺取精是为了保证能够获得可用精子,而且为了保证取出精子的质量,男性在取精前需要做的准备也是较多的,这里分享几点尤为...

睾丸穿刺取精的手术费用详解,全程下来不会高于三千元!
在生殖领域上面,大家对于睾丸穿刺手术肯定是不陌生的,主要在做人工授精和试管婴儿手术中会应用到,当然有些可能是自我取精的,但是对于一些特殊的患者就需要通过睾丸穿刺手术进行取精,这样才能培养胚胎。当然,现目前在临床上面还是通过睾丸穿刺手术取精,从而评估睾丸功能。不过现目前,很多的人对于这项手术不太了解,所以下面就来给大家说说具体的。什么是睾丸穿刺手术睾丸穿刺指的是一种活性体检检测注射,全称叫做经皮睾丸...

一篇文章告诉你睾丸穿刺术有多痛,附五大步骤分享
睾丸穿刺取精会有一些疼痛感,但都是可以忍受的,通常会打麻药,全麻或局麻,而且整个过程需要的时间也很短,只要几分钟就可以了,具体要做几次需要看精子的质量,如果精子质量好的话,做一次就可以了,如果不好的话,有的就需要做两次甚至是更多。睾丸穿刺取精手术1、对于阻塞性无精症及存在射精障碍的患者,需要先进行附睾局部皮肤消毒,局部麻醉后,用5毫升注射器经皮直接穿刺附睾抽吸附睾液,或显微外科小手术的方法切开附睾...

显微镜下睾丸穿刺无精是什么原因?
睾丸穿刺无精子的原因有很多,其中最常见的,就是生活习惯不良导致的,这种情况一般规律作息并且配合治疗就能恢复。再来还可能是先天性生殖器官疾病导致无精,这种情况是非常难治愈的,只能尝试治疗看效果。另外输精管堵塞也可能会导致睾丸穿刺无精子,这种情况可以通过手术治疗恢复。睾丸穿刺无精子引起的原因很复杂,有可能是先天性不能产生精子,也有可能是生殖器炎症所造成的无精症状,下面就为大家具体介绍睾丸穿刺无精子是怎...

无精不进行睾丸穿刺能直接申请供精吗?
非梗阻性无精子症要做睾丸穿刺,活检明确发现没有成熟精子时才可以申请供精助孕。一般如果只是精液检查发现无精症,是不能直接做供精的,这种情况如果通过治疗或睾丸穿刺手术可以找到精子的话,那就有生育自己的孩子的可能。非梗阻性无精子症患者主要是因为睾丸生精功能严重受损或完全缺失,但通过手术取精获得精子的概率大约为50%,所以能取到精就可以冷冻保存精子,用来做试管婴儿。我老公也是无精症,当时医生给我们说无精症...

看了又看